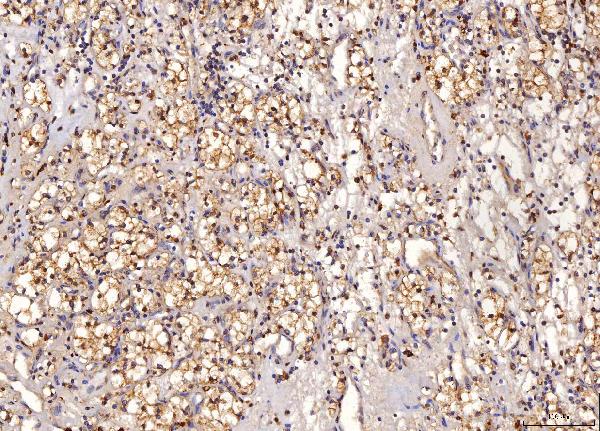

Anti-Sorbitol Dehydrogenase/SORD Antibody Picoband™ (monoclonal, 12B10G2)
- SPECIFICATION
- CITATIONS
- PROTOCOLS
- BACKGROUND

Application
| WB, IHC, FC |
|---|---|
| Primary Accession | Q00796 |
| Host | Mouse |
| Isotype | Mouse IgG1 |
| Reactivity | Rat, Human, Mouse |
| Clonality | Monoclonal |
| Format | Lyophilized |
| Description | Anti-Sorbitol Dehydrogenase/SORD Antibody Picoband™ (monoclonal, 12B10G2) . Tested in Flow Cytometry, IHC, WB applications. This antibody reacts with Human, Mouse, Rat. |
| Reconstitution | Adding 0.2 ml of distilled water will yield a concentration of 500 µg/ml. |
| Gene ID | 6652 |
|---|---|
| Other Names | Sorbitol dehydrogenase, SDH, 1.1.1.-, (R, R)-butanediol dehydrogenase, 1.1.1.4, L-iditol 2-dehydrogenase, 1.1.1.14, Polyol dehydrogenase, Ribitol dehydrogenase, RDH, 1.1.1.56, Xylitol dehydrogenase, XDH, 1.1.1.9, SORD |
| Calculated MW | 40 kDa |
| Application Details | Western blot, 0.25-0.5 µg/ml, Human, Mouse, Rat Immunohistochemistry(Paraffin-embedded Section), 2-5 µg/ml, Human, Rat Flow Cytometry, 1-3 µg/1x10^6 cells, Human |
| Contents | Each vial contains 4 mg Trehalose, 0.9 mg NaCl and 0.2 mg Na2HPO4. |
| Clone Names | Clone: 12B10G2 |
| Immunogen | E.coli-derived human Sorbitol Dehydrogenase/SORD recombinant protein (Position: N8-P357). |
| Purification | Immunogen affinity purified. |
| Storage | At -20°C for one year from date of receipt. After reconstitution, at 4°C for one month. It can also be aliquotted and stored frozen at -20°C for six months. Avoid repeated freezing and thawing. |
| Name | SORD |
|---|---|
| Function | Polyol dehydrogenase that catalyzes the reversible NAD(+)- dependent oxidation of various sugar alcohols. Is mostly active with D- sorbitol (D-glucitol), L-threitol, xylitol and ribitol as substrates, leading to the C2-oxidized products D-fructose, L-erythrulose, D- xylulose, and D-ribulose, respectively (PubMed:3365415). Is a key enzyme in the polyol pathway that interconverts glucose and fructose via sorbitol, which constitutes an important alternate route for glucose metabolism. The polyol pathway is believed to be involved in the etiology of diabetic complications, such as diabetic neuropathy and retinopathy, induced by hyperglycemia (PubMed:12962626, PubMed:25105142, PubMed:29966615). May play a role in sperm motility by using sorbitol as an alternative energy source for sperm motility (PubMed:16278369). May have a more general function in the metabolism of secondary alcohols since it also catalyzes the stereospecific oxidation of (2R,3R)-2,3-butanediol. To a lesser extent, can also oxidize L-arabinitol, galactitol and D-mannitol and glycerol in vitro. Oxidizes neither ethanol nor other primary alcohols. Cannot use NADP(+) as the electron acceptor (PubMed:3365415). |
| Cellular Location | Mitochondrion membrane {ECO:0000250|UniProtKB:Q64442}; Peripheral membrane protein {ECO:0000250|UniProtKB:Q64442}. Cell projection, cilium, flagellum {ECO:0000250|UniProtKB:Q64442}. Note=Associated with mitochondria of the midpiece and near the plasma membrane in the principal piece of the flagellum. Also found in the epididymosome, secreted by the epididymal epithelium and that transfers proteins from the epididymal fluid to the sperm surface. {ECO:0000250|UniProtKB:Q64442} |
| Tissue Location | Expressed in liver (PubMed:3365415). Expressed in kidney and epithelial cells of both benign and malignant prostate tissue. Expressed in epididymis (at protein level) |

Thousands of laboratories across the world have published research that depended on the performance of antibodies from Abcepta to advance their research. Check out links to articles that cite our products in major peer-reviewed journals, organized by research category.
info@abcepta.com, and receive a free "I Love Antibodies" mug.
Provided below are standard protocols that you may find useful for product applications.
Background
Sorbitol dehydrogenase is an enzyme that in humans is encoded by the SORD gene. Sorbitol dehydrogenase (SORD) catalyzes the interconversion of polyols and their corresponding ketoses, and together with aldose reductase, makes up the sorbitol pathway that is believed to play an important role in the development of diabetic complications. The first reaction of the pathway (also called the polyol pathway) is the reduction of glucose to sorbitol by ALDR1 with NADPH as the cofactor. SORD then oxidizes the sorbitol to fructose using NAD(+) cofactor.
If you have used an Abcepta product and would like to share how it has performed, please click on the "Submit Review" button and provide the requested information. Our staff will examine and post your review and contact you if needed.
If you have any additional inquiries please email technical services at tech@abcepta.com.





Foundational characteristics of cancer include proliferation, angiogenesis, migration, evasion of apoptosis, and cellular immortality. Find key markers for these cellular processes and antibodies to detect them.
The SUMOplot™ Analysis Program predicts and scores sumoylation sites in your protein. SUMOylation is a post-translational modification involved in various cellular processes, such as nuclear-cytosolic transport, transcriptional regulation, apoptosis, protein stability, response to stress, and progression through the cell cycle.
The Autophagy Receptor Motif Plotter predicts and scores autophagy receptor binding sites in your protein. Identifying proteins connected to this pathway is critical to understanding the role of autophagy in physiological as well as pathological processes such as development, differentiation, neurodegenerative diseases, stress, infection, and cancer.